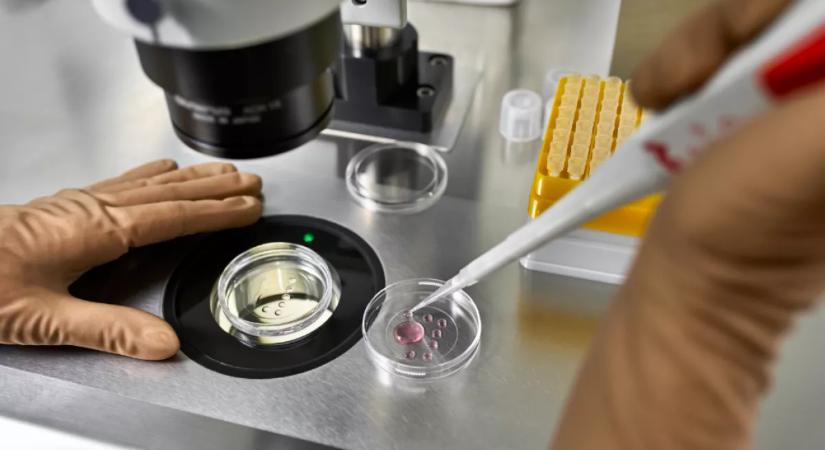
Lombikbébi program után: amikor meglátta a babát, azonnal DNS-tesztet követelt

Lombikbébi program után: amikor meglátta a babát, azonnal DNS-tesztet követelt
Amikor világra jött a kislány, a szülők rögtön érezték, itt valami nagyon nincs rendben. A DNS-teszt mindent megerősített.
Hamarosan átirányítunk a teljes cikkhez → TWN